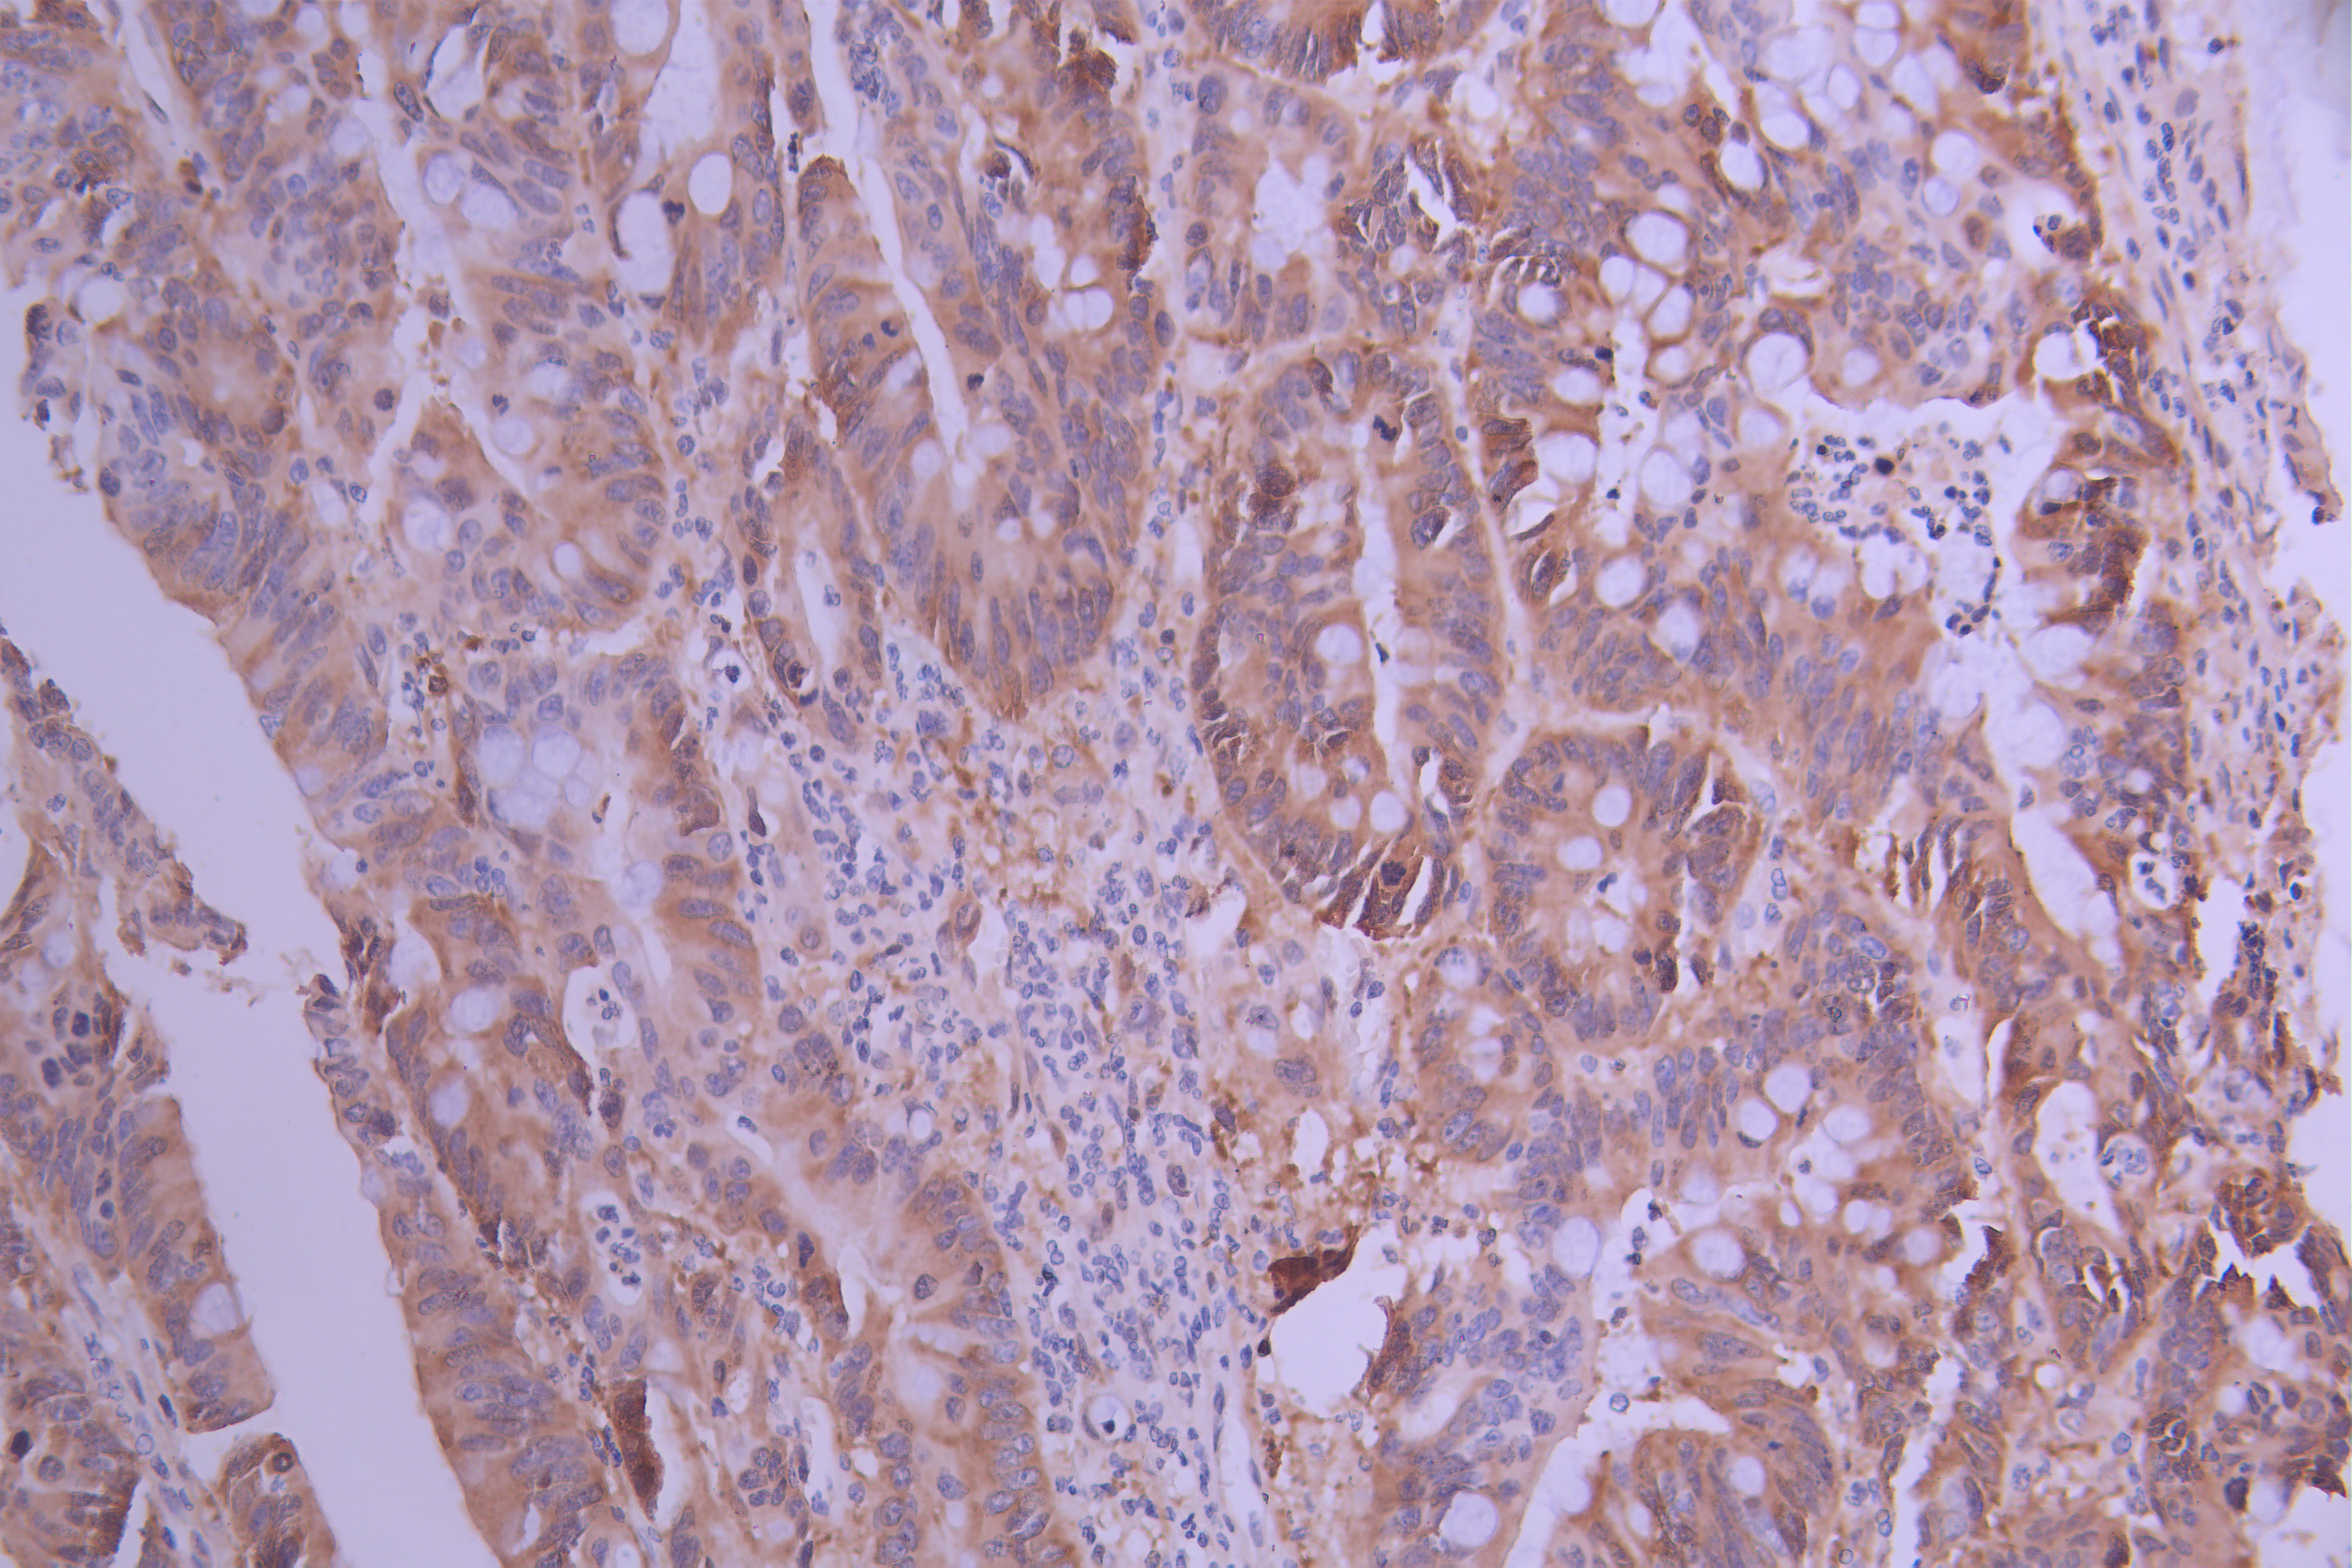

RRM1 Recombinant Monoclonal Antibody
-
中文名稱:RRM1 Recombinant Monoclonal Antibody
-
貨號:CSB-RA786202A0HU
-
規(guī)格:¥1320
-
圖片:
-
Western Blot
Positive WB detected in: PC-3 whole cell lysate(30μg), K562 whole cell lysate(30μg), A549 whole cell lysate(30μg), SW620 whole cell lysate(30μg), HEK293 whole cell lysate(30μg), HepG2 whole cell lysate(30μg), Hela whole cell lysate(30μg), NIH/3T3 whole cell lysate(30μg)
All lanes: RRM1 antibody at 1:1000
Secondary
Goat polyclonal to rabbit IgG at 1/40000 dilution
Predicted band size: 90 kDa
Observed band size: 90 kDa
Exposure time:1min -
IHC image of CSB-RA786202A0HU diluted at 1:100 and staining in paraffin-embedded human colorectal cancer performed on a Leica BondTM system. After dewaxing and hydration, antigen retrieval was mediated by high pressure in a citrate buffer (pH 6.0). Section was blocked with 10% normal goat serum 30min at RT. Then primary antibody (1% BSA) was incubated at 4°C overnight. The primary is detected by a Goat anti-rabbit polymer IgG labeled by HRP and visualized using 0.05% DAB.
-
Overlay Peak curve showing Hela cells stained with CSB-RA786202A0HU (red line) at 1:100. The cells were fixed in 4% formaldehyde and permeated by 0.2% TritonX-100 for 10min. Then 10% normal goat serum to block non-specific protein-protein interactions followed by the antibody (1ug/1*106cells) for 45min at 4℃. The secondary antibody used was FITC-conjugated goat anti-rabbit IgG (H+L) at 1/200 dilution for 35min at 4℃.Control antibody (green line) was Rabbit IgG (1ug/1*106cells) used under the same conditions. Acquisition of >10,000 events was performed.
-
-
其他:
產(chǎn)品詳情
-
Uniprot No.:
-
基因名:RRM1
-
別名:R1 antibody; Ribonucleoside diphosphate reductase large subunit antibody; Ribonucleoside diphosphate reductase M1 chain antibody; Ribonucleoside diphosphate reductase subunit M1 antibody; Ribonucleoside reductase; large subunit antibody; Ribonucleoside-diphosphate reductase large subunit antibody; Ribonucleoside-diphosphate reductase subunit M1 antibody; Ribonucleotide reductase large chain antibody; Ribonucleotide reductase large subunit antibody; Ribonucleotide reductase M1 antibody; Ribonucleotide reductase M1 polypeptide antibody; Ribonucleotide reductase R1 subunit antibody; Ribonucleotide reductase; M1 subunit antibody; RIR 1 antibody; RIR1 antibody; RIR1_HUMAN antibody; RR 1 antibody; RR1 antibody; RRM 1 antibody; RRM1 antibody
-
反應(yīng)種屬:Human, Mouse
-
免疫原:A synthesized peptide derived from human RRM1
-
免疫原種屬:Homo sapiens (Human)
-
標(biāo)記方式:Non-conjugated
-
克隆類型:Monoclonal
-
抗體亞型:Rabbit IgG
-
純化方式:Affinity-chromatography
-
克隆號:7D10
-
濃度:It differs from different batches. Please contact us to confirm it.
-
保存緩沖液:Rabbit IgG in 10mM phosphate buffered saline , pH 7.4, 150mM sodium chloride, 0.05% BSA, 0.02% sodium azide and 50% glycerol.
-
產(chǎn)品提供形式:Liquid
-
應(yīng)用范圍:ELISA, WB, IHC, FC
-
推薦稀釋比:
Application Recommended Dilution WB 1:500-1:2000 IHC 1:50-1:200 FC 1:50-1:200 -
Protocols:
-
儲存條件:Upon receipt, store at -20°C or -80°C. Avoid repeated freeze.
-
貨期:Basically, we can dispatch the products out in 1-3 working days after receiving your orders. Delivery time maybe differs from different purchasing way or location, please kindly consult your local distributors for specific delivery time.
-
用途:For Research Use Only. Not for use in diagnostic or therapeutic procedures.
相關(guān)產(chǎn)品
靶點詳情
-
功能:Provides the precursors necessary for DNA synthesis. Catalyzes the biosynthesis of deoxyribonucleotides from the corresponding ribonucleotides.
-
基因功能參考文獻(xiàn):
- The evaluation of RRM1 gene expression in cfRNA allows for estimation of the risk of severe oral mucositis (OM) in patients subjected to radiotherapy PMID: 29865035
- The expression of RRM1 can be considered a predictor of poor survival in patients with pancreatic cancer receiving gemcitabine chemotherapy. PMID: 29214667
- Our results therefore demonstrate that RRM1 is a novel therapeutic target in multiple myeloma in the preclinical setting and provide the basis for clinical evaluation of RRM1 inhibitor, alone or in combination with DNA-damaging agents, to improve patient outcome in multiple myeloma PMID: 28442502
- three SNPs (corepressor interacting with RBPJ 1 (CIR1) rs13009079T>C, ribonucleotide reductase M1 (RRM1) rs1465952T>C and solute carrier family 38, member 4 (SLC38A4) rs2429467C>T), may play a role in the pathogenesis of lung cancer PMID: 27587543
- TP53 mutant cancer cells had elevation of ribonucleotide reductase subunit 1 (RRM1) and 2 (RRM2), which was reduced by inhibition of mTORC1. PMID: 28507282
- The genetic polymorphisms RRM1 -756T>C and -269C>A may not be a factor for susceptibility to cervical neoplasia PMID: 27179014
- Based on the results of clinical trials, we conclude that Ribonucleotide reductase (RR) enzymes (RR1 and RR2)inhibitors are viable treatment options, either as a monotherapy or as a combination in cancer chemotherapy. With the recent advances made in cancer biology, further development of RR inhibitors with improved efficacy and reduced toxicity is possible for treatment of variety of cancers. PMID: 28624910
- RRM1 single nucleotide polymorphism is associated with Non-Small-Cell Lung Cancer. PMID: 27908619
- RRM1/RRM2B enzyme is capable of retaining activity in hypoxia and therefore is favored over RRM1/RRM2 in order to preserve ongoing replication and avoid the accumulation of DNA damage in hypoxic cells. PMID: 28416140
- findings suggest that the up-regulated RRM1 and hTrx1 in colorectal cancer directly interact with each other and promote RR activity, resulting in enhanced DNA synthesis and cancer malignancy. PMID: 28411237
- RRM1 and ERCC1 expression levels did not show any relationship with overall survival. PMID: 26612755
- RRM1 and ERCC wild type alleles are risk-reducing factor for Coronary artery disease (CAD). Also, carrying RRM1 A allele might have a protective effect for smokers. PMID: 27566080
- Presence of rare AA (-37C>A) and CC (-524C>T) genotypes of the RRM1 may be favorable predictive factors for chemotherapy with platinum compounds and gemcitabine in non-small cell lung cancer patients. PMID: 26650486
- study finds that ERCC1 and RRM1 are not independent prognostic factors of recurrence in stage I non-small cell lung cancer patients PMID: 26542178
- mRNA expression of RRM1 was closely associated with cell proliferation and varied in seven non-Hodgkin lymphoma cell lines. PMID: 27173327
- A significant association has been found between RRM1 rs12806698 (-269C>A) RRM1 genotype and the risk for developing non-small cell lung cancer. PMID: 26718430
- Results underline the relevance of microRNA-101-3p-driven regulation of RRM1 in pancreatic ductal carcinoma gemcitabine resistance. PMID: 26828016
- The genotype of ribonucleotidereductase M1 -269C > A is associated with the response to platinum-based chemotherapy and as a prognostic biomarker in advanced nonsmall cell lung cancer PMID: 26323924
- TUBB3, TOP2A, CYP19A1 and CYP2D6 gene expression, but not protein expression, was associated with patient survival. PMID: 26252353
- A possible predictive impact of ribonucleotide-reductase subunit-1 (RRM1) on vinorelbine efficacy in non-small cell lung cancer (NSCLC) has been previously reported. PMID: 26637889
- RRM1 expression was predictive and prognostic of clinical outcome in advanced UC treated with gemcitabine plus platinum combination chemotherapy PMID: 26200905
- RNA expression of deoxycytidine kinase (DCK), human equilibrative nucleoside transporter-1 (ENT1) and ribonucleotide reductase M1 (RRM1) were significantly higher and cytidine deaminase (CDA) was significantly lower in ex vivo Ara-C sensitive samples. PMID: 26083014
- It is an effective target to overcome gemcitabine resistance in gemcitabine-resistant pancreatic cancer cells. PMID: 25837929
- For RRM1 C37A-T524C genotype, sensitive group had higher proportion of high effective genotype than non-sensitive group (p=0.009). PMID: 26028097
- Adenoviral vector expressing short hairpin RNA targeting RRM1 exerts potent antitumor effects and increases sensitivity to gemcitabine. PMID: 26254808
- Data demonstrate that RRM1 gene interferes with mitotane metabolism in adrenocortical cancer cells, as a possible mechanisms of drug resistance. PMID: 25497672
- These in vitro results suggest that mRNA expression levels of the RRM1 and ABCB1 genes may be useful indicators of chemosensitivity to gemcitabine and cisplatin. PMID: 25560468
- The oligomerization-directed fluorescence quenching of hRNR-alpha, covalently labeled with two fluorophores, allows for direct readout of hRNR dimeric and hexameric states. PMID: 25256246
- RRM1 expression was identified as independent prognosticators for freedom from recurrence of malignant pleural mesothelioma in patients undergoing induction chemotherapy followed by extrapleural pneumonectomy. PMID: 25840756
- In Turkish population RRM1 rs12806698 carriers have nearly twofold risk for development of head and neck squamous epithelial cell cancer. PMID: 24861915
- Patients with high RRM1 expression benefited more from a platinum-containing regimen, and patients with high BRCA1 expression showed a high response rate to a platinum-containing regimen and reduced disease progression. PMID: 25078585
- Gene polymorphisms of RRM1 -756T>C and RRM1 -269C>A may be not an important factor for the susceptibility of breast cancer. PMID: 24578158
- concomitant low expression levels of ERCC1, RRM1, and RRM2 and the high expression level of BRCA1 were predictive of a better outcome. PMID: 25227663
- RRM1 gene expression may contribute to chemotherapy sensitivity and may be an indicator of survival in nonsmall cell lung cancer patients treated with gemcitabine plus cisplatin. PMID: 24591771
- RRM1 IHC expression tailored selection of first-line therapy could improve therapeutic outcomes in patients with advanced NSCLC. PMID: 24595080
- High intratumoural hENT1 and low RRM1 expression were independently associated with prolonged disease-free survival in cholangiocarcinoma patients treated with adjuvant gemcitabine-based chemotherapy. PMID: 25032731
- High RRM1 expression is associated with non-small cell lung cancer. PMID: 23803067
- No change in RRM1 expression was observed in primary NSCLC tumours, but expression seemed to be higher in N2 lymph node metastases following chemotherapy. PMID: 24266856
- Ribonucleotide reductase large subunit M1 predicts poor survival due to modulation of proliferative and invasive ability of gastric cancer. PMID: 23922955
- we found no support of the hypothesis that aberrations of RRM1 or RRM2B, neither individually nor in combination, are associated with an altered clinical outcome following chemotherapy. PMID: 24215511
- We observed an increase of ORR in NSCLC patients when they were treated with chemotherapy according to ERCC1 and RRM1 SNPs status. PMID: 24045016
- low expression of RRM1 and RRM2 could be used to predict the treatment response to platinum-based chemotherapy and survival in non-small cell lung cancer PMID: 24155212
- RRM1 preserves chromosomal stability via the CHK1- and CDK1-dependent stabilization of the centrosomal integrity at the replication stage. PMID: 24434653
- Genetic polymorphisms in SLC28A3, SLC29A1 and RRM1 can influence the clinical outcome of metastatic breast cancer patients treated with paclitaxel-gemcitabine chemotherapy. PMID: 24361227
- The analysis of RRM1 (-37C>A) more than ERCC1 (19007C>T) polymorphism may be a promising tool in the qualification of NSCLC patients for chemotherapy containing platinum compounds and gemcitabine PMID: 23982437
- These results suggest that SNPs within ribonucleotide reductase (RRM1 and RRM2) might be helpful predictive markers of response to nucleoside analogs and should be further validated in larger cohorts. PMID: 24024897
- Low RRM1 expression is associated with response to therapy in pancreatic cancer. PMID: 23991987
- RR1 expression may discriminate cervical cancer phenotype and radiochemotherapy outcome PMID: 23552804
- The expressions of MDR-1, RRM-1, EGFR, ERCC-1 were observed in a variety of pathological types of NSCLC. PMID: 23948418
- Report essential roles for ribonucleotide reductase and thymidylate synthase in C-MYC-dependent suppression of senescence in melanoma cells. PMID: 23249808
顯示更多
收起更多
-
亞細(xì)胞定位:Cytoplasm.
-
蛋白家族:Ribonucleoside diphosphate reductase large chain family
-
數(shù)據(jù)庫鏈接:
Most popular with customers
-
YWHAB Recombinant Monoclonal Antibody
Applications: ELISA, WB, IHC, IF, FC
Species Reactivity: Human, Mouse, Rat
-
Phospho-YAP1 (S127) Recombinant Monoclonal Antibody
Applications: ELISA, WB, IHC
Species Reactivity: Human
-
-
-
-
-
-